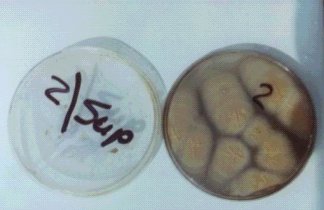

|
|
AbstractBackground: Patients with abnormally-looking nails, while clinically suggestive of onychomycosis, often yield negative cultures for dermatophytes or pathogenic yeasts. In many of those cases, colonization by non-dermatophyte molds is frequently observed.
Aim: This study was carried out to estimate the prevalence of non-dermatophyte molds in Egyptian patients presenting clinically with abnormal nails.
Patients & Methods: From 32 cases (14 males and 18 females) with different nail abnormalities, nail clippings and nail scrapings were obtained. Both microscopic examination (20% potassium hydroxide mounts) and culture on Sabouraud's dextrose agar medium with and without cycloheximide were used for species identification.
Results: Non-dermatophyte molds were isolated from 19 cases (59.4%). Members of the genus
Aspergillus were the commonest among them (47%). Dermatophytes were detected in only five patients (15.6%), including species of
Microsporum canis and Trichophyton violaceum. Yeasts were isolated in only three patients (9.4%), whereas 15.6 % did not grow any fungus in culture.
Conclusion: This study suggests that nails rendered abnormal by various pathologies are frequently colonized by non-dermatophyte molds, and that the prevalence may vary according to the environment or geographic distribution. They should not be overlooked when evaluating such cases with nail abnormalities.
Introduction Nail disfigurement is a common presentation in dermatologic practice, which manifests as a change in shape, surface, color or nail attachment. Fungal infection of the nails, the most common cause in adults, is often difficult to be differentiated clinically from primary nail diseases such as psoriasis.
Dermatophytes are usually assumed as the principal causative agents of abnormal nails. However, dermatologists are frequently faced with treatment failure, and microbiologists are frequently faced with failure to isolate dermatophytes in culture, this may be due to a possible infection by non-dermatophyte molds (NDMs).
NDMs are filamentous fungi that are commonly found in nature as soil saprophytes and plant pathogens [1]. It is not known whether infection with NDMs can occur as a primary infection on healthy nails or exist only as secondary invaders living saprophytically in nail plates already damaged by trauma, ischemia or other diseases especially dermatophyte infection. NDMs regularly identified in onychomycosis include
Scytalidium species (spp.), Scopulariopsis, Fusarium, Acremonium and Aspergillus spp.[2].
Aim
This study was carried out to estimate the prevalence of NDMs in Egyptian patients presenting clinically with abnormal nails. This may help better evaluate the significance of these fungi and their possible contribution to the clinical problem of nail disfigurement.
Patients and Methods
The study was carried out on 32
patients; 14 males and 18 females, with mean age 40 years,
with different nail abnormalities attending the out-patient
clinic of the Department of Dermatology at Kasr El-Aini
hospital. Inclusion criteria for nail abnormalities included:
subungual hyperkeratosis, nail thickening, longitudinal and
transverse grooves, pitting, brittle nails, cracks, changes
in color of nail plates such as black, yellow, and white
discoloration and onycholysis. Patients who had received
antifungal treatment during the preceding four weeks were
excluded. For each patient the following was done:
1) A full history taking including past and present history of fungal infections and any other associated medical disease, trauma and previous treatment schedules. The onset, course and duration of the nail lesions with or without skin lesions were recorded.
2) A general skin examination was performed.
3) A local examination was done searching for any finger and/or toe nail abnormalities according to the criteria of inclusion. All 20 nails were examined. In clinically suspected onychomycosis, the extent of involvement and the portion of nail involved in the process, were noted. Associated erythema, swelling or tenderness were looked for.
4) Nail clippings and nail scrapings of the affected part of the nail unit were obtained from all cases. All specimens were subjected to:
a) Microscopic examination using 20% potassium hydroxide (KOH) preparation. The material was placed on a glass slide and 20% KOH was added. The addition of dimethyl sulfoxide (DMSO) to KOH solution was often helpful because of the thickness of the debris. The glass slide was heated for a minute or so under a cover glass then examined microscopically for the presence of fungal elements: spores and hyphae.
b) Duplicate cultures: each specimen was inoculated on Sabouraud's dextrose agar chloramphenicol medium with and without cyclohexamide. Chloramphenicol was added to reduce contamination, and cyclohexamide was added to detect the presence of dermatophytes, inhibiting NDMs growth. The plates were incubated at 27°C for four weeks. Examination of fungal colonies on different plates was done for growth morphology, colonial appearance, surface texture, shape, size, color, rate of growth, undersurface and edge.
c) A wet mount preparation of the growth was stained by lactophenol cotton blue stain for easier visualization and examination of fungal elements and the identification of conidia morphology and arrangement.
Results
1- Clinical data (Table 1):
|
Patients |
n=32 |
|
Age |
16-72 years, |
|
mean 39.2years |
|
Sex |
14 males (43.75%) |
|
18 females (56.25%) |
|
Residence |
Urban, n=20 (62%) |
|
Rural, n=12 (38%) |
|
Occupation |
High risk: housewives, butchers, farmers and workers, n=
18. |
|
Low risk: office workers, n= 14 |
|
Extent of affection |
Some nails of fingers and toes, n=31 |
|
Some nails of toes only,
n=1 |
|
Primary complaint |
Nail disfigurement, n=12
(38%) |
|
Other dermatological
complaint, n=20(62%) |
Table 1: Summary of clinical data of patients with
abnormal nails.
2- Results of direct microscopy using KOH (table 2):
Direct microscopic examination of the 32 specimens was done using 20% KOH. Seven patients (22%) were KOH positive and 25 patients (78%) were negative.
|
Culture on Sabouraud’s
agar
|
|
Case no. |
KOH |
With C. H |
Without C. H |
Case no. |
KOH |
With C. H |
Without C.H |
|
1 |
-ve |
NG |
A. niger |
17 |
-ve |
N G |
NG |
|
|
|
|
|
|
|
|
|
|
2 |
-ve |
NG |
A. fumigatus |
18 |
-ve |
N G |
P. nonatum |
|
3 |
-ve |
NG |
NG |
19 |
+ve |
N G |
A. niger |
|
4 |
+ve |
NG |
P. nonatum |
20 |
-ve |
N G |
A. niger |
|
5 |
-ve |
NG |
NG |
21 |
-ve |
N G |
C. albicans |
|
6 |
+ve |
NG |
C. albicans |
22 |
-ve |
N G |
NG |
|
7 |
-ve |
T. violaceum |
NG |
23 |
-ve |
N G |
A. niger |
|
8 |
-ve |
NG |
A. fumigatus |
24 |
-ve |
N G |
NG |
|
9 |
-ve |
NG |
A. flavus |
25 |
+ve |
M. canis |
NG |
|
10 |
-ve |
M. canis |
N G |
26 |
-ve |
N G |
A. flavus |
|
11 |
-ve |
N G |
P. nonatum |
27 |
-ve |
N G |
A. flavus |
|
12 |
+ve |
N G |
A. fumigatus |
28 |
+ve |
N G |
A. flavus |
|
13 |
-ve |
N G |
A. terreus+flavus |
29 |
-ve |
N G |
A. fumigatus |
|
14 |
-ve |
N G |
A. niger |
30 |
-ve |
N G |
P. nonatum |
|
15 |
-ve |
M. canis |
NG |
31 |
-ve |
T. violaceum |
NG |
|
16 |
-ve |
N G |
Alternaria alternata |
32 |
+ve |
N G |
C. albicans |
CH = Cycloheximide NG = No growth
T. =
Trichophyton species
M. = Microsporum species A. =
Aspergillus
species P. = Penicillum species
C. = Candida species
Table 2:
Results of direct microscopy and culture on Sabouraud’s
dextrose agar with and without cycloheximide
3- Results of fungal culture on SDA with and without cycloheximide (table 2):
Culture plates were examined after four weeks macroscopically, and microscopically for the identification of the conidia morphology (type and arrangement), figures (1-4).
|
 |
|
Figure (1) Lactophenol cotton
blue stain of Aspergillus flavus. |
|
 |
|
Figure (2) Lactophenol cotton
blue stain of Aspergillus fumigatus showing the
conidiophore having a swollen end called a vesicle (flask
shaped).
|
|
 |
|
Figure (3) Culture of
Alternaria alternata on Sabouraud's dextrose agar.
|
|
|
|
 |
|
Figure (4) Lactophenol cotton blue stain of
Penicillium nonatum showing the brush appearance.
|
Twenty two patients (68.75%) had a positive culture without cycloheximide; where 19 patients (59.38%) yielded NDMs and 3 patients (9.38%) yielded candidal growth, all candida albicans. Only five patients (15.6%) had a positive culture with cycloheximide ( two patients grew
Trichophyton
violaceum and three patients Microsporum canis). The remaining five patients had no growth on either type of culture.
Among the 32 patients, 19 of them were found infected with NDMs and are shown in table [3]; with Aspergillus species in 14 patients (46.87%),
Alternaria alternata species in 1 patient (3.13%) and
Penicillium nonatum species in 4 patients (12.5%).
The different Aspergillus species detected in the study were: A. niger (5 patients; 35.71%), A. flavus (4 patients; 28.57%), A. fumigatus (4 patients; 28.57% ), From one single patient, A. flavus and A.
terreus were isolated simultaneously in the same culture.
Certain types of NDMs were not detected in this study such as Scopulariopsis brevicaulis, Acremonium spp., Scytalidium spp. and Fusarium spp. Those seven patients who had a positive KOH preparation also yielded positive culture, where one was positive for dermatophytes, two for candida and four for NDMs.
In this study, no significant epidemiological factors were found to predispose to colonization of clinically abnormal nails by NDMs, as regards age, sex, residence and occupation.
DiscussionIn this study 32 patients were included, amongst them only 12 were seeking medical advice for their nail disfigurement, whereas the majority visited the outpatient clinic for various dermatologic complaints. This occurred because they did not think it was indicating a disease, or because of previous treatment failures, they thought it was an incurable condition. NDMs are not easily identified with routine fungal cultures, and if discovered, they need a much longer duration of therapy with systemic antifungal agents than dermatophytes, which patients do not always receive. Thus, we carried out this study in order to detect the possible prevalence of NDM in patients with abnormal nails. Almost 60% of the total number of our cases were positive for non-dermatophytes.
Non-dermatophyte molds are filamentous fungi that are commonly found in nature as soil saprophytes and plant pathogens [1]. The NDMs which are regularly identified invading the nails are: Scopulariopsis brevicaulis, Scytalidium spp., Fusarium spp., Acremonium spp., Aspergillus spp., and Onychocola
canadensis [2]. Suggested predisposing factors include increasing age, immunosuppression, poor peripheral circulation, peripheral neuropathy and trauma [3].
Direct microscopy using KOH preparation plays an important role in diagnosing nail fungal infections. However, fungal culture is the only definitive test that can be used to identify the species of the infectious organism [4]. Unfortunately, microscopy is often negative in nails that appear to be infected clinically. Moreover, cases may yield positive culture in spite of negative direct microscopy using KOH, as in 20 of our cases. This could be explained by the absence of hyphae from the specimen collected for microscopic examination. In that case the fungus might have been in an inactive sporulating phase that is difficult to be detected by KOH, but can grow molds when cultured on the appropriate medium. Furthermore, nails that are positive by microscopic examination may sometimes yield negative cultures. A possible reason for this discrepancy is that fungi seen on KOH examination may not be viable by the time they are inoculated in vitro and hence do not grow as expected [5]. Also, sampling the nail beyond the distal tip may not yield positive cultures because the infection advances proximally and the fungal elements at the distal end of the nail are less likely to be viable [6].
Certain studies stated that the polymerase chain reaction [7] and histopathologic examination with periodic acid-Schiff stain [8] may be more sensitive methods for detection and identification of onychomycosis than conventional methods, and have considerable diagnostic value.
We carried out our study on 32 patients with different nail abnormalities in order to estimate the prevalence of NDMs. They represented 19 (59.38%) of our cases. The prevalence of NDMs varies considerably among several reports in the literature. In another study of 1548 patients affected by nail disorders it was found that nail invasion by NDM is considered uncommon with prevalence rates ranging from 1.45% to 17.6% [1]. Even in known cases of onychomycosis, only a minority of cases were attributed to NDMs, e.g. 5% [9] and 8.2% [10]. In Egypt, Khafagy et al. [11], who studied 207 Egyptian cases of onychomycosis, isolated NDMs in a higher percentage (50%) of their cases. This variation may reflect geographic differences in mold distribution.
The genus Aspergillus was the most common species detected in this study among the NDMs with an isolation rate of 43.75% (14 patients). Comparable high isolation rates of this genus of fungi was also reported by Khafagy et al.[11] in Egypt and Ramani et al. [12] in India with a rate of almost 40% in both studies. This maybe explained by the presence of this species in some tropical and temperate areas as a predominant one.
The genus Penicillium was detected in four specimens representing 12.5% of the total cases. Genus Alternaria was detected in one specimen representing 3.13% of the total number of cases which is considered a high prevalence in Egypt. Certain types of NDMs were not detected in this study such as Scopulariopsis brevicaulis spp., Acremonium spp. Scytalidium spp. and Fusarium spp.
In a large-scale North American study of fungal isolates from the nails to detect the frequency of onychomycosis, it was found that NDMs and yeasts represented 20 % each. Acremonium, Fusarium, and Scopulariopsis spp., were the most common isolates among the NDMs (representing 29.5 %, 34.1 %, and 20 % of non-dermatophyte isolates respectively). Scytalidium spp., represented approximately 4.5 %, and Aspergillus spp., represented approximately 11.36% of the NDMs [13].
Comparable results were described, where the prevalence of NDMs in onychomycosis in Italy represented 13.9 %. Fusarium spp., were the most common non-dermatophyte isolates and represented 44 % of the non-dermatophyte isolates. Scopulariopsis brevicaulis represented 28.8 %, Acremonium spp., represented 15.25 % and
Aspergillus spp., represented 11.86 % of the non-dermatophyte isolates [1].
Most reports worldwide detect dermatophytes in cases of abnormal nails and in known cases of onychomycosis [1,10,12]. In this study dermatophytes were detected in only five patients including species of
Microsporum canis and Trichophyton
violaceum. All patients positive for dermatophytes did not grow NDMs in the culture of their nail clippings. One possible explanation of this phenomenon is the presence of antibiosis between dermatophytes and NDMs, so that when dermatophytes are prevalent the growth of NDMs is inhibited.
Yeasts represented 9.38% of the total number of our cases, which is considered lower than Khafagy et al.[1], who isolated yeasts in 34.4% of their cases, and also lower than the American [13] and European statistics [1].
It is difficult to determine the role of NDMs as primary pathogens of the nail apparatus. Studies are required to evaluate their ability to invade intact healthy nails, which is a known characteristic of dermatophytes. However, it is conceivable to speculate that NDMs can colonize nails that are damaged by trauma, other dermatologic conditions such as psoriasis or lichen planus, or by other keratinophilic dermatophytes, thereby contributing to clinical presentation of dystrophic nails.
In our study, no significant factors were found to predispose to NDM colonization as regards age, sex, residence and occupation using non-parametric tests.
This is in contrast to other authors, who found that the subject's age was a strong risk factor[13,14,15]. It was suggested that the higher incidence of onychomycosis in patients older than 55 years may be due to the greater tendency of younger patients to seek treatment at an earlier stage [14]. Male subjects were found to have twice [13] or thrice [16] as likely onychomycosis as female subjects, which they attributed to the suggestion that ''men exercise more" [16]. Sais [17] found the exact opposite to be true, suggesting that trauma from wearing women's fashionable shoes might account for the difference. Others [14] found the incidence rate to be the same between the sexes.
We conclude that NDMs should be considered in evaluating and treating abnormal nails. But, their incrimination as a primary cause of onychomycosis must be confirmed by excluding other predisposing factors as dystrophic nails in cases of peripheral vascular disease or in diabetics. Epidemiological investigations should be performed in every country in order to determine the fungal species associated with abnormal nails.
References
1. Tosti A, Piraccini BM and Lorenzi S. Onychomycosis caused by non-dermatophytic molds. J Am Acad Dermatol.; 42:217, 2000.
2. Gupta AK, Horgan-Bell CB and Summerbell RC. Onychomycosis associated with Onychocola canadienesis: Ten cases reports and a review of the literature. J Am Acad Dermatol.; 39:410, 1998.
3. Elewski BE. Diagnostic techniques for confirming onychomycosis. J Am Acad Dermatol.; 35:S6, 1996.
4. Tasic S, Stojanovic S and Poljacki M. Etiopathogenesis, clinical picture and diagnosis of onychomycosis. Med Pregl.; 54:45, 2001.
5. Midgley G, Moore MK, Cook C and Phan QG. Mycology of nail disorders. J Am Acad Dermatol.; 31: S68, 1994.
6. Shelley WB and Wood MG. The white spot target for microscopic examination of nails for fungi. J Am Acad Dermatol.; 6:92, 1982.
7. Baek SC, Chae HJ, Houh D, Byun DG, and Cho BK. Detection and differentiation of causative fungi of onychomycosis using PCR amplification and restriction enzyme analysis. Int J Dermatol.; 37: 682, 1998.
8. Lawry MA, Haneke E, Strobeck K, Martin S, Zimmer B and Romano PS. Methods for diagnosing onychomycosis: a comparative study and review of the literature. Arch Dermatol.; 136:1112, 2000.
9. Denning DW, Evans EVG, Kibbler CC, Richardson MD, Roberts MM, Rogers TR, Warnock DW and Warren RF. Fungal nail disease: a guide to good practice. Br Med J.; 311:1277, 1995.
10. Khosravi AR and Mansouri P. Onychomycosis in Tehran, Iran: prevailing fungi and treatment with itraconazole. Mycopathologia.; 150:9, 2001.
11. Khafagy N, Taha M and El-Gothamy Z. Onychomycosis: Etiological Study. J Pan-Arab League of Dermatologists.; 9:61, 1998.
12. Ramani R, Srinivas CR, Ramani A Kumari TGR and Shivanada PG. Molds in onychomycosis. Int J Derm; 32:877, 1993.
13. Ghannoum MA, Hajjeh RA, Scher R, Konnikov N, Gupta AK, Summerbell R, Sullivan S, Daniel R, Krusinski P, Fleckman P, Rich P, Odom R, Aly R, Pariser D, Zaiac M, Rebell G, Lesher J, Gerlach B, Ponce-De-Leon GF, Ghannoum A, Warner J, Isham N and Elewski B. A large-scale North American study of fungal isolates from nails. J Am Acad Dermatol.; 43:641, 2000.
14. Roberts DT. Prevalence of dermatophyte onychomycosis in the United Kingdom: results of an omnibus survey. Br J Dermatol.; 39:23, 1992.
15. Gupta AK, Scher RK and De Doncker P. Current management of onychomycosis. Dermatol Clin.; 15: 121, 1997.
16. Heikkila H and Stubb S. The prevalence of onychomycosis in Finland. Br J Dermatol.; 133:699, 1995.
17. Sais G, Jucgla A and Peyri J. Prevalence of dermatophyte onychomycosis in Spain: a cross-sectional study. Br J Dermatol., 132:758, 1995.
© 2006 Egyptian Dermatology
Online Journal
|